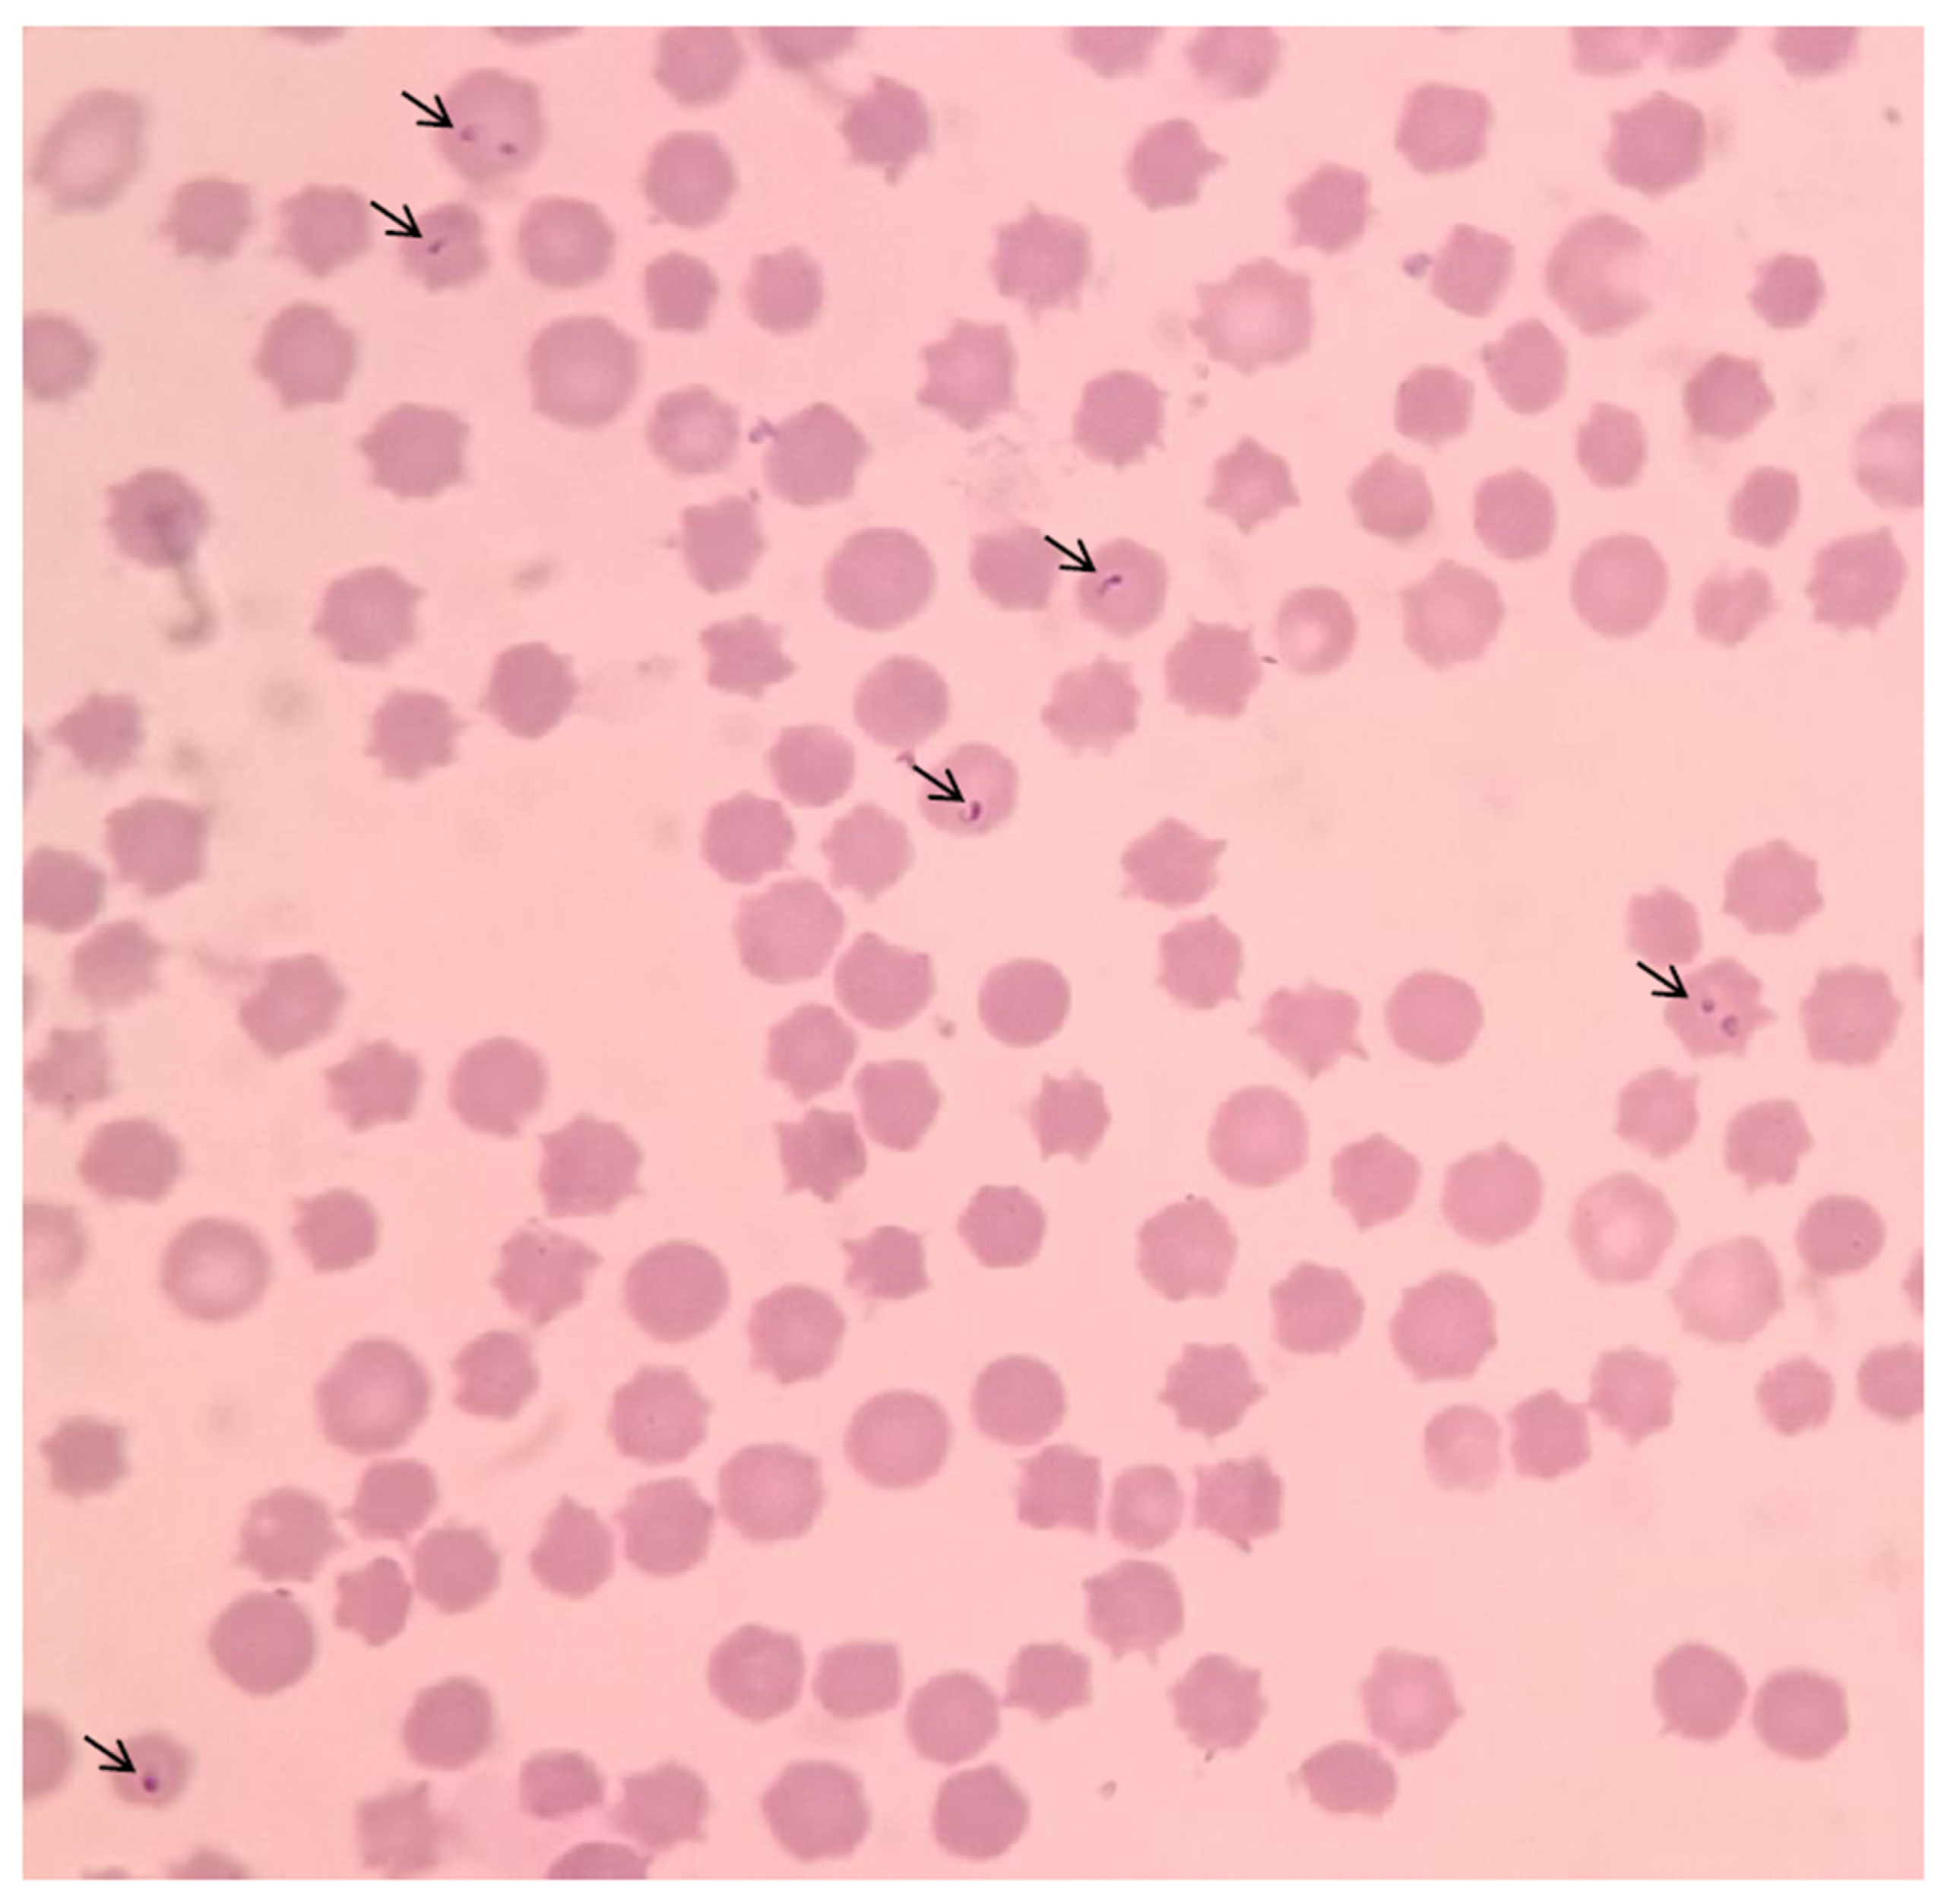
Preprints 77104 g002

Submitted:
20 June 2023
Posted:
20 June 2023
You are already at the latest version
Abstract
Keywords:
1. Introduction
2. Materials and Methods
2.1. Ethics Statement
2.2. Tick Collection and DNA Extraction
2.3. Cattle Experiment
2.4. Blood Genome Extraction and PCR Amplification
2.5. Sequence Analysis and Phylogenetic Tree
2.6. Sample Testing
3. Result
3.1. Pathological Replication
3.2. Pathological Examination
3.3. PCR Detection and Sequencing
3.4. Sequence Analysis and Evolutionary Tree
3.5. Sample Detection
4. Discussion
5. Conclusions
Author Contributions
Funding
Acknowledgments
References
- Hakimi, H.; Asada, M.; Ishizaki, T.; Kawazu, S. Isolation of viable Babesia bovis merozoites to study parasite invasion. Sci Rep 2021, 11, 16959. [Google Scholar] [CrossRef] [PubMed]
- Giglioti, R.; Okino, C.H.; Azevedo, B.T.; Wedy, B.C.R.; Gutmanis, G.; Veríssimo, C.J.; Katiki, L.M.; Filho, A.E.V.; de Oliveira, H.N.; Oliveira, M.C.S. Semi-quantitative evaluation of Babesia bovis and B. bigemina infection levels estimated by HRM analysis. Ticks Tick Borne Dis 2021, 12, 101753. [Google Scholar] [CrossRef]
- Cuy-Chaparro, L.; Reyes, C.; Díaz-Guiot, E.V.; Moreno-Pérez, D.A.; Patarroyo, M.A. Developing Anti-Babesia bovis Blood Stage Vaccines: A New Perspective Regarding Synthetic Vaccines. Int J Mol Sci 2023, 24, 5219. [Google Scholar] [CrossRef]
- Alvarez, J.A.; Rojas, C.; Figueroa, J.V. An Overview of Current Knowledge on in vitro Babesia Cultivation for Production of Live Attenuated Vaccines for Bovine Babesiosis in Mexico. Front Vet Sci 2020, 7, 364. [Google Scholar] [CrossRef] [PubMed]
- Álvarez Martínez, J.A.; Figueroa Millán, J.V.; Ueti, M.W.; Rojas-Martínez, C. Establishment of Babesia bovis In Vitro Culture Using Medium Free of Animal Products. Pathogens 2021, 10, 770. [Google Scholar] [CrossRef] [PubMed]
- Brown, W.C.; Norimine, J.; Knowles, D.P.; Goff, W.L. Immune control of Babesia bovis infection. Vet Parasitol 2006, 138, 75–87. [Google Scholar] [CrossRef]
- Hidalgo-Ruiz, M.; Mejia-López, S.; Pérez-Serrano, R.M.; Zaldívar-Lelo de Larrea, G.; Ganzinelli, S.; Florin-Christensen, M.; Suarez, C.E.; Hernández-Ortiz, R.; Mercado-Uriostegui, M.A.; Rodríguez-Torres, A.; Carvajal-Gamez, B.I.; Camacho-Nuez, M.; Wilkowsky, S.E.; Mosqueda, J. Babesia bovis AMA-1, MSA-2c and RAP-1 contain conserved B and T-cell epitopes, which generate neutralizing antibodies and a long-lasting Th1 immune response in vaccinated cattle. Vaccine 2022, 40, 1108–1115. [Google Scholar] [CrossRef]
- Githaka, N.W.; Bishop, R.P.; Šlapeta, J.; Emery, D.; Nguu, E.K.; Kanduma, E.G. Molecular survey of Babesia parasites in Kenya: first detailed report on occurrence of Babesia bovis in cattle. Parasit Vectors 2022, 15, 161. [Google Scholar] [CrossRef]
- Guglielmone, A.A. Epidemiology of babesiosis and anaplasmosis in South and Central America. Vet Parasitol 1995, 57, 109–19. [Google Scholar] [CrossRef]
- Li, Y.; Guan, G.; Ma, M.; Liu, J.; Ren, Q.; Luo, J.; Yin, H. Theileria ovis discovered in China. Exp Parasitol 2011, 127, 304–7. [Google Scholar] [CrossRef]
- Gou, H.; Guan, G.; Liu, A.; Ma, M.; Xu, Z.; Liu, Z.; Ren, Q.; Li, Y.; Yang, J.; Chen, Z.; Yin, H.; Luo, J. A DNA barcode for Piroplasmea. Acta Trop 2012, 124, 92–7. [Google Scholar] [CrossRef] [PubMed]
- Kumar, S.; Stecher, G.; Li, M.; Knyaz, C.; Tamura, K. MEGA X: Molecular Evolutionary Genetics Analysis across Computing Platforms. Mol Biol Evol 2018, 35, 1547–1549. [Google Scholar] [CrossRef]
- Mahdy, O.A.; Nassar, A.M.; Elsawy, B.S.M.; Alzan, H.F.; Kandil, O.M.; Mahmoud, M.S.; Suarez, C.E. Cross-sectional analysis of Piroplasma species-infecting camel (Camelus dromedaries) in Egypt using a multipronged molecular diagnostic approach. Front Vet Sci 2023, 10, 1178511. [Google Scholar] [CrossRef] [PubMed]
- Oliveira-Sequeira, T.C.; Oliveira, M.C.; Araujo, J.P. , Jr Amarante, A.F. PCR-based detection of Babesia bovis and Babesia bigemina in their natural host Boophilus microplus and cattle. Int J Parasitol 2005, 35, 105–11. [Google Scholar] [CrossRef] [PubMed]
- El-Sayed, S.; Rizk, M.A.; Terkawi, M.; Igarashi, I. Cocktail Babesia bovis antigens for global detection of Babesia bovis infection in cattle. Exp Parasitol 2019, 206, 107758. [Google Scholar] [CrossRef] [PubMed]
- Eamens, G.J.; Bailey, G.; Jenkins, C.; Gonsalves, J.R. Significance of Theileria orientalis types in individual affected beef herds in New South Wales based on clinical, smear and PCR findings. Vet Parasitol 2013, 196, 96–105. [Google Scholar] [CrossRef] [PubMed]
- Zhang, X.L.; Deng, Y.P.; Yang, T.; Li, L.Y.; Cheng, T.Y.; Liu, G.H.; Duan, D.Y. Metagenomics of the midgut microbiome of Rhipicephalus microplus from China. Parasit Vectors 2022, 15, 48. [Google Scholar] [CrossRef] [PubMed]
- Kumar, R.; Sharma, A.K.; GhoshS. Menace of acaricide resistance in cattle tick, Rhipicephalus microplus in India: Status and possible mitigation strategies. Vet Parasitol 2020, 278, 108993. [Google Scholar] [CrossRef]
- Makenov, M.T.; Toure, A.H.; Korneev, M.G.; Sacko, N.; Porshakov, A.M.; Yakovlev, S.A.; Radyuk, E.V.; Zakharov, K.S.; Shipovalov, A.V.; Boumbaly, S.; Zhurenkova, O.B.; Grigoreva, Y.E.; Morozkin, E.S.; Fyodorova, M.V.; Boiro, M.Y.; Karan, L.S. Rhipicephalus microplus and its vector-borne haemoparasites in Guinea: further species expansion in West Africa. Parasitol Res 2021, 120, 1563–1570. [Google Scholar] [CrossRef]
- Gómez, G.F.; Isaza, J.P.; Segura, J.A.; Alzate, J.F.; Gutiérrez, L.A. Metatranscriptomic virome assessment of Rhipicephalus microplus from Colombia. Ticks Tick Borne Dis 2020, 11, 101426. [Google Scholar] [CrossRef]
- Ramos, C.M.; Cooper, S.M.; Holman, P.J. Molecular and serologic evidence for Babesia bovis-like parasites in white-tailed deer (Odocoileus virginianus) in south Texas. Vet Parasitol 2010, 172, 214–20. [Google Scholar] [CrossRef] [PubMed]

| Species | Isolate | Accession No. | Identity | Species | Isolate | Accession No. | Identity |
|---|---|---|---|---|---|---|---|
| B. bovis | Chongqing | No | ![]() |
B. bovis | Yunnan | KY805830 | 96.39 |
| B. bovis | Yunnan | MN252438 | 96.31 | B. bovis | Hunan | JQ723013 | 95.16 |
| B. bovis | Yunnan | MN252440 | 95.50 | B. bovis | North | KP710223 | 94.48 |
| B. bovis | Shannxian | AY603398 | 95.41 | B. bovis | Turkey | KP745628 | 94.11 |
| B. bovis | Jilin | MN900523 | 95.82 | B. bovis | Argentina | MH569534 | 94.49 |
| B. bovis | Spain | FJ426364 | 94.84 | B. bovis | Germany | EF458213 | 94.49 |
| B. bovis | South Africa | MH257724 | 96.23 | B. bovis | Australia | JQ437260 | 95.08 |
| B. bovis | USA | MH046907 | 96.15 | B. bovis | Cuba | MN053043 | 95.90 |
| B. bovis | Portugal | KP745628 | 94.11 | B. bovis | Bolivia | LC645224 | 95.54 |
| B. bovis | India | KF928959 | 95.82 | B. bigemina | Yunnan | MH208614 | ![]() |
| Province | Rhipicephalus microplus ticks (Number) | Babesia Bovis Positive (%) |
|---|---|---|
| Guangxi | 186 | 12.40(n=23) |
| Yunnan | 356 | 17.70(n=63) |
| Fujian | 136 | 0 |
| Qinghai | 225 | 10.67(n=24) |
| Gansu | 358 | 18.44(n=66) |
| Chongqing | 178 | 21.35(n=38) |
| Shandong | 246 | 9.75(n=24) |
| Henan | 83 | 0 |
| Total | 1768 | 13.46(n=238) |
Disclaimer/Publisher’s Note: The statements, opinions and data contained in all publications are solely those of the individual author(s) and contributor(s) and not of MDPI and/or the editor(s). MDPI and/or the editor(s) disclaim responsibility for any injury to people or property resulting from any ideas, methods, instructions or products referred to in the content. |
© 2023 by the authors. Licensee MDPI, Basel, Switzerland. This article is an open access article distributed under the terms and conditions of the Creative Commons Attribution (CC BY) license (http://creativecommons.org/licenses/by/4.0/).
